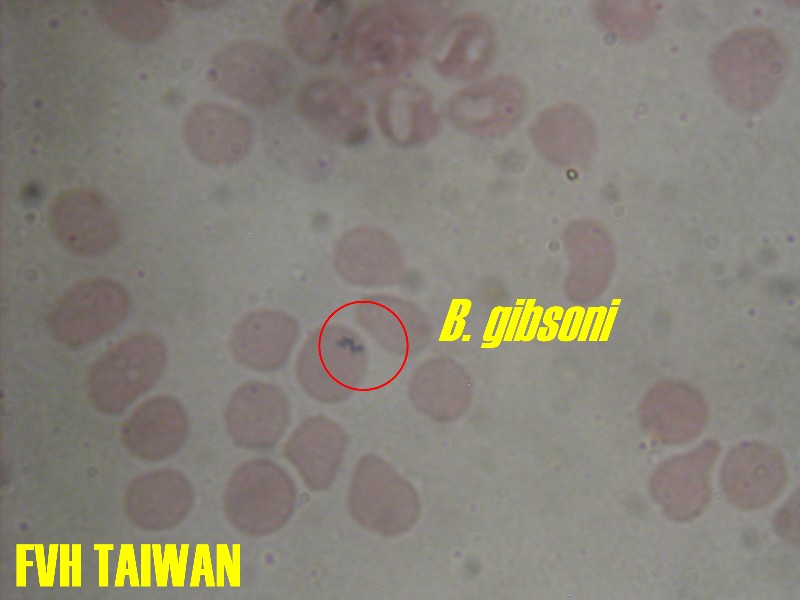

|
|
|
|
|
 |
貓腎臟多發性囊腫
貓咪體重減輕,食慾不振,右腹部膨大...
<詳細內容> |
 |
貓子宮蓄膿
貓咪多飲多尿,食慾不振,腹部膨大...
<詳細內容> |
|
|
|
|
|
|
 手術照片 手術照片
|
犬子宮蓄膿
狗狗食慾不振、精神不佳、多飲多尿、腹部膨大、陰道有膿樣分泌物......
 內有手術照片<詳細內容> 內有手術照片<詳細內容>
|
 手術照片 手術照片
|
最危險節育手術
如此危險的節育狀況是貓貓狗狗都應極力避免的:終止懷孕。
 內有手術照片<詳細內容> 內有手術照片<詳細內容>
|
|
|
|
|
 |
貓前肢骨折
貓咪自六樓高的公寓墜落,意識清醒,外傷情況嚴重...
<詳細內容> |
 |
犬水蛭入鼻
狗狗食慾精神正常,但鼻孔裡似乎有暗黑色的鼻涕...
<詳細內容> |
|
|
|
|
 |
犬膀胱結石
狗狗食慾不振,精神不佳,頻尿,先前常有血尿現象...
 內有手術照片<詳細內容> 內有手術照片<詳細內容>
|
 |
犬乳腺腫瘤
狗狗右側第四乳房有腫塊,且有不正常傷口出現...
<詳細內容> |
|
|
|
|
 |
犬口臭嚴重牙結石
狗狗食慾不振、口臭、一直流口水...
<詳細內容> |
 |
犬睪丸腫瘤
狗狗的陰囊腫大,且有疼痛現象...
 內有手術照片<詳細內容> 內有手術照片<詳細內容>
|
|
|
|
|
 |
犬齒槽膿漏
左眼瞼下方有開放性傷口,滲出帶血膿液,兩至三週無法癒合...
 內有手術照片<詳細內容> 內有手術照片<詳細內容>
|

|
犬乳腺腫瘤復發
曾於其他動物醫院接受乳腺腫瘤切除手術,兩個月內又發現有數個腫塊,且有疼痛現象...
<詳細內容> |
|
|
|
|
 |
犬皮膚腫瘤
腫塊表面皮膚有傷口、並有紅色血樣分泌物...
 內有手術照片<詳細內容> 內有手術照片<詳細內容>
|
|
犬大小焦蟲
病犬來院做健康檢查時發現,黏膜蒼白,腹圍腫大(主犬檢查是否懷孕),呼吸倉卒.消瘦等等症狀.
<詳細內容>
|